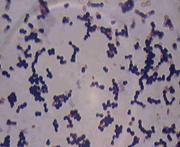

Адаптация пропионовокислых бактерий и пригодность дрожжей к производству плодовых вин
Реферат
Адаптация
пропионовокислых бактерий и пригодность дрожжей к производству плодовых вин
Адаптация бактерий к неблагоприятным условиям
среды является сегодня самым изучаемым разделом биохимии и микробиологии. Под
адаптацией понимают сумму физиологических, биохимических, морфологических и
поведенческих реакций организма, направленных на изменение скорости роста,
метаболизма и жизнеспособности (выживаемости). В настоящей работе освещены
современные представления о механизмах стрессовых ответов пропионовокислых
бактерий и влияния внеклеточных факторов прокариот ни их адаптацию к
неблагоприятным условиям среды - к повышенной концентрации солей.
Целью исследований является изучение
устойчивости пропионовокислых бактерий к поваренной соли.
В первой серии опытов изучали влияние хлорида
натрия на биохимическую активность. Об активности биохимических процессов
судили по нарастанию биомассы и росту клеток пропионовокислых бактерий,
подсчитанных в конце процесса ферментации. Результаты исследований представлены
в таблице 1 и на рисунке 1.
Таблица 1 − Влияние хлорида натрия на рост
пропионовокислых бактерий
|
Штамм
|
Количество
жизнеспособных клеток (КОЕ/см3) при добавлении NaCl
в питательную среду в следующих количествах:
|
|
контроль
|
2
%
|
4
%
|
6
%
|
8
%
|
|
1
|
2
|
3
|
4
|
5
|
6
|
|
Propionibacterium freudemrichiisubsp.
fredenreichii АС-2500
|
1*1010
|
6*1012
|
12*1010
|
1*1010
|
|
Propionibacterium
cyclohexanicum
Kusano АС-2260
|
1*109
|
5*108
|
1*1010
|
2*107
|
1*107
|
|
Propionibacterium
cyclohexanicum
Kusano АС-2259
|
16*108
|
1*109
|
3*108
|
1*108
|
1*108
|
Установлено, что наиболее устойчивый к NaCl
штамм пропионовокислых бактерий является Propionibacterium
freudemrichii
subsp. fredenreichii
АС-2500, который сохраняет значительное количество живых клеток (1010-1012) КОЕ
в 1 см3 при достаточно высоких концентрациях соли в питательной среде.
Так как скорость роста является интегральным
показателем состояния микроорганизмов, на следующем этапе определяли влияние
хлорида натрия на скорость роста пропионовокислых бактерий. Для этого
анализировали кривые роста бактерий в координатах А590 − T, где А590 - ОП
культуральной жидкости при 590 нм, T -время культивирования.
Из рисунка 1 видно, что во всех изучаемых
штаммах происходит замедление роста по сравнению с контролем. Критическим
является концентрация хлорида натрия 8 %, при которой происходит резкое
снижение скорости роста по сравнению с другими концентрациями.

Таким образом, Propionibacterium freudemrichii subsp. fredenreichii АС-2500
является наиболее устойчивым из всех исследуемых штаммов пропионовокислых
бактерий. У данного штамма происходит наименьшее замедление скорости роста и он
сохраняет значительное количество клеток в питательной среде при достаточно
высоких концентрациях соли. Этот штамм может быть использован в тех отраслях
пищевой промышленности, где используются довольно высокие концентрации соли,
например в мясной и сыродельной.
Адаптация факторов внешней среды
обеспечивается механизмами, гарантирующими стабильность микробного консорциума.
К механизмам относятся межклеточные взаимодействия - связи (когезия) и прочное
прикрепление клеток к субстрату (адгезия).
В литературе имеются единичные
сведения, освещающие межклеточные контакты микроорганизмов и образование в
дальнейшем сложных многоклеточных систем. Что касается пропионовокислых
бактерий, то работы, посвященные изучению роли межклеточной коммуникации, в
связи со стрессовыми воздействиями нами не обнаружены.
Когезия пропионовокислых бактерий -
это защитная реакция микроорганизмов (в частности против излишней солености
питательной среды) что было подтверждено экспериментально. Межклеточные
взаимодействия пропионовокислых бактерий выращенных на среде с разным
содержанием хлорида натрия представлены на рисунках 2−6.
Как видно из рисунков 2−6, при
низких концентрациях соли (2 %), когезия бактерий была минимальна (рисунок 3).
С увеличением солености до 4 % количество агрегированных клеток резко возросло.
Клеточные агрегаты представляют собой скопления клеток неправильной формы
(рисунок 4).
Наибольшее скопление клеток
наблюдалось у пропионовокислых бактерий Propionibacterium freudemrichiisubsp. fredenreichii АС-2500 и Propionibacterium cyclohexanicum Kusano АС-2259 при
содержании соли 4 %. Дальнейшее увеличение солености до 6% привело к небольшой
дезагрегации клеток, а при солености 8% дезагрегационные процессы клеток у Propionibacterium freudemrichiisubsp. fredenreichii АС-2500 и Propionibacterium cyclohexanicum Kusano АС-2259
усилились. Степень их когезии была примерно как при 2 % солености среды. У
пропионовокислых бактерий Propionibacterium cyclohexanicum Kusano АС-2260 при
повышении солености от 2 до 8 % отмечается увеличение агрегации клеток.


cyclohexanicum Propionibacterium
cyclohexanicum Propionibacterium freudemrichiiАС-2259 Kusano
АС-2260
subsp. fredenreichii АС-2500
Рисунок 2 - Когезия штаммов
пропионовокислых бактерий, выращенных на среде, не содержащей хлорида натрия


Propionibacterium cyclohexanicum Propionibacterium cyclohexanicum Propionibacterium freudemrichii
Kusano АС-2259 Kusano АС-2260 subsp. fredenreichii АС-2500
Рисунок 3 - Когезия штаммов
пропионовокислых бактерий выращенных на среде, содержащей 2 % хлорида натрия

Propionibacterium cyclohexanicum Propionibacterium cyclohexanicum Propionibacterium freudemrichii
Kusano АС-2259 Kusano АС-2260 subsp. fredenreichii АС-2500
Рисунок 4 - Когезия штаммов
пропионовокислых бактерий выращенных на среде, содержащей 4 % хлорида натрия
бактерия адаптация
микробный сок


Propionibacterium
cyclohexanicum Propionibacterium cyclohexanicum Propionibacterium freudemrichiiАС-2259
Kusano АС-2260
subsp. fredenreichii АС-2500
Рисунок 5 - Когезия штаммов
пропионовокислых бактерий выращенных на среде, содержащей 6 % хлорида натрия
Propionibacterium cyclohexanicum Propionibacterium cyclohexanicum Propionibacterium freudemrichii
Kusano АС-2259 Kusano АС-2260 subsp. fredenreichii АС-2500
Рисунок 6 - Когезия штаммов
пропионовокислых бактерий выращенных на среде, содержащей 8 % хлорида натрия
Полученные данные позволяют
утверждать, что особенности роста пропионовокислых бактерий в экстремальных
условиях могут представлять собой специальную стратегию выживания, основанную
социальным поведением популяции микроорганизмов. Вероятно, что в условиях
межклеточных контактов, агрегация клеток поддерживает их жизнеспособность. Это
подтверждается данными, полученные нами при исследовании удельной скорости
роста и жизнеспособности клеток пропионовокислых бактерий, в зависимости от
солености среды.
Кроме того, посредством внеклеточных
факторов адаптации возможно межвидовое взаимодействие микроорганизмов,
бифидобактерий и пропионовокислых бактерий.
Таким образом, внеклеточные факторы
адаптации играют важную роль не только в адаптации отдельных клеток
пропионовокислых бактерий к неблагоприятным условиям, но также обеспечивает
химическую коммуникацию в популяции для ее выживания и является средством
кооперации в сообществах.
В настоящее время в условиях
Алтайского края весьма перспективным направлением является производство
высококачественного вина на плодовой основе, достойные органолептические
показатели которого обеспечиваются рядом факторов. В частности, климатическими
условиями района произрастания, имеющейся сырьевой базой и грамотно проведенным
процессом брожения.
Однако коренное улучшение качества
плодовых вин, повышение их конкурентоспособности возможно лишь на основе
глубокого изучения биохимических, микробиологических процессов,
основополагающая роль в которых принадлежит дрожжам.
Сбраживание соков на дикой
микрофлоре нежелательно, так как при этом неизбежны разного рода случайности,
такие как недоброд спирта, большая потеря органических кислот, сверхнормативное
накопление летучих кислот, инфицированность готового вина нежелательными
микроорганизмами [2].
Для подавления нежелательной
микрофлоры в промышленности в качестве основного возбудителя брожения
используют культурные дрожжи, обладающие ценными производственными свойствами.
Cбраживание
плодовых соков ранее проводилось с использованием жидких разводок чистых
культур дрожжей Saccaromyces vini, использование которых
позволяло обеспечить полноту выбраживания и микробиологическую чистоту процесса
брожения [1]. Вместе с тем, их применение связано с низкими сроками хранения
жидких разводок, высокой трудоемкостью процесса воспроизводства дрожжей,
недостаточной стабильностью качественных показателей готового продукта. В
последние годы в винодельческой промышленности используют препараты активных
сухих дрожжей (АСД), производимые за рубежом.
Использование АСД имеет ряд
существенных преимуществ, связанных с обеспечением стандартных
органолептических показателей вин, значительным увеличением сроков хранения
дрожжей и возможностью непосредственного внесения их в сусло.
Существует большое количество рас
АСД, отобранных и используемых в производстве, однако применительно к плодовому
виноделию, с учетом специфики биохимического состава местного сырья, проблема
отбора рас чистых культур дрожжей остается не решенной, что определяет
актуальность наших исследований.
Нами проведена оценка пригодности
французских рас АСД: Франс Вайт, Франс Универсал, Франс Суперстарт, № 67 J INRA
NARBONNE для выработки высококачественных плодовых вин из местного сырья.
Приемка, отбор проб и методы испытаний
осуществлялись в соответствии с ГОСТ Р 51144-98. Для аналитических исследований
использованы методы: массовая концентрация сахара - методом прямого титрования
(ГОСТ 13192-73), объемная доля этилового спирта - по удельному весу отгона
(ГОСТ Р 54653-2000), летучие кислоты - по ГОСТ Р 51654-2000, сухие растворимые
вещества - рефрактометрическим методом (ГОСТ 28262-90), титруемая кислотность -
потенциометрическим методом (ГОСТ Р 51624-200), сернистая кислота - методом
прямого йодометрического титрования (ГОСТ Р 51655-2000), рН -
потенциометрическим методом на иономере ЭВ-74.
Брожение проводили в стеклянных
сосудах емкостью 1 л, укупоренных ватными пробками, при температуре 18-23 °С. В
качестве антиоксиданта и антисептика вносили метабисульфит калия из расчета 75
мг/дм3. Исследования проведены в лаборатории технологии переработки плодов и
ягод ГНУ НИИСС им. М.А. Лисавенко в 2010 г.
Испытание рас дрожжей проводили на
натуральном свежеотжатом яблочном соке в трех повторностях. Параллельно
поставлены опыты по сбраживанию яблочного сока дикой дрожжевой микрофлорой.
Критерием оценки рас дрожжей были
эффективность брожения (скорость накопления спирта, процент несброженного
сахара) и функция размножения клеток. Кроме того, определяли содержание летучих
кислот, титруемой кислотности, рН.
Начало забраживания сока быстрее
всего наблюдалось у рас Франс Вайт и Франс Суперстарт − на первые сутки,
расы Франс Универсал и № 67 J INRA NARBONNE на вторые и третьи сутки
соответственно. Позже всех, на четвертые сутки забродил сок на дикой дрожжевой
микрофлоре.
Процесс роста и развития дрожжевых
клеток, а также накопления ими биомассы неравномерен. Наибольшая биомасса
накоплена дрожжами расы Франс Суперстарт (67 млн./мл), наименьшая - дрожжами
расы № 67 J INRA NARBONNE (16 млн./мл). В большинстве случаев от скорости
размножения дрожжей зависели полнота сбраживания сахара и количество
накопленного спирта.
Рисунок 7 - Накопление спирта
испытуемыми расами АСД
Изменение тируемой кислотности и рН
незначительно во всех случаях. Самая длительная продолжительность брожения
отмечена в соках, сброженных дикими дрожжами - 17 дней, применение АСД рас
Франс Суперстарт и Франс Универсал позволило сократить продолжительность
брожения до семи дней.
Дрожжевая микрофлора соков,
сброженных на культурных расах, чистая, без бактериального загрязнения. Микрофлора
соков, сброженных на диких дрожжах, представлена мелкими заостренными и
пленчатыми дрожжами, кокками. Кроме того, при спонтанном сбраживании в
виноматериалах отмечен посторонний привкус и нехарактерный аромат.
Виноматериалы, приготовленные с
использованием французских рас АСД, отличались высокими органолептическими
показателями.
Выводы
Для первичного сбраживания плодовых
соков целесообразно использовать АСД расы Франс Суперстарт, позволяющие
добиться максимально возможного накопления спирта, сокращения процесса брожения
до семи дней и сохранения сортовых особенностей вина.
Литература
1. Бурьян,
Н.И. Микробиология виноделия / Н.И. Бурьян. Институт винограда и вина «Магарач»
Украинской академии аграрных наук. − Ялта, 2007.
- 431 с.
. Кишковский,
З.Н. Технология вина / З.Н. Кишковский, А.А. Мержаниан. − М.: Легкая и
пищевая промышленность, 2004.
- 504 с.